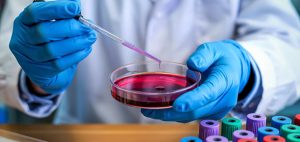

AI-Driven Customized Solutions for Life Sciences
Empowering pharma, biotech, and providers, with advanced AI-driven solutions across the drug discovery and development continuum.
The life sciences industry stands at the crossroads of groundbreaking innovation and immense operational complexity. From high-stakes race to develop life-saving therapies to the intricate demands of scaling production, organizations face mounting challenges: siloed operations, costly inefficiencies, and the relentless need for faster, data-driven decisions. Emerging modalities and evolving regulations further complicate the path to progress- there is no room for error and latency in discovery, development, and delivery!
mcube™ for Life Sciences
At TCG Digital we are empowering life sciences companies to overcome these hurdles by combining advanced AI, robust data operations, and domain expertise. Our solutions accelerate drug discovery, optimize manufacturing processes, and ensure compliance, helping you bring therapies to market faster and more efficiently. At the heart of it lies mcube™ built at the intersection of pharmaceutical innovation, domain mastery, and technological excellence. By integrating powerful knowledge graphs, mcube™ brings unmatched precision, deriving interconnected insights from complex datasets, enabling accurate predictions, and optimizing processes across the drug discovery and development continuum.
Our Clientele
Trusted by leading pharma and biotech firms, mcube™ combines innovative technology with tailored solutions to enhance operational efficiency and drive better outcomes.
ADMA Biologics
Optimizing Biopharmaceutical Manufacturing with AI-powered ADMAlytics™.Through our partnership with ADMA Biologics, we delivered:
Read MoreLess
- Over $1M in annual savings.
- 30% efficiency gains from automation and AI.
- Enhanced inventory visibility, enabling strategic forward planning.
A Global Biopharma Leader
Transforming R&D and Drug Discovery with mcube™ – based integrated AI solutions:
Read MoreLess
- PK Assay Analysis, leading to $1.3 million in annual cost savings
- PK Assay Analysis with multiplex, leading to $0.8 million in annual cost savings
- Genotyping Analysis, leading to $0.5 million in annual cost savings
- Gene Expression Analysis, leading to $0.5 million in annual cost savings
Global Biotech Company
Maximizing Bioanalytics ROI with AI-driven solutions. Creating an integrated analytics workflow for Genmab on mcube™; solutions deployed:
Read MoreLess
- PK Assay Analysis, has driven operational efficiencies, reducing manual intervention and associated errors
- ADA Assay Analysis, resulted in improved manpower efficiency, reduced rework costs, and enhanced compliance
- Method Validation, achieved increased efficiency, reduced rework, and improved compliance with regulatory standards.
- ICH M10 Complaint Reporting Solution, helped Genmab streamline their reporting processes, ensuring they remain compliant with regulatory standards and enhance their overall operational efficiency
Who We Serve
Research & Clinical Development
Empowering life sciences R&D teams with scientific data lakehouse, seamless assay analytics, and AI-driven insights to accelerate breakthroughs and streamline operations, turning complexity into opportunity.
Biopharma Manufacturing
Scaling bio-pharma manufacturing while managing product variability, ensuring peak quality, and adhering to strict compliance is more challenging than ever. We are tackling this head-on, integrating Data & AI to optimize processes, ensure consistency, and maintain the highest standards, empowering the industry to scale with confidence and precision.
CDMO
Navigating the complexities of scaling production, managing product variability, and upholding the highest standards of quality and compliance is paramount for CDMOs. Our advanced AI-driven solutions empower CDMOs to streamline operations, ensure batch consistency, meet diverse client demands, and achieve manufacturing excellence at scale.
Hospitals
We empower hospitals with an integrated performance management system with 500+ pre-built KPIs that optimize critical hospital operations from re-admissions to bed utilization, patient outcomes, staffing, inventory, and satisfaction metrics. In an environment where legacy systems and data silos hinder efficiency, our solution enables seamless integration and unified visibility across the enterprise.
Our Numbers Speak Volumes
50% Faster Turnaround
Seamlessly integrated with your LIMS for swift, error-free assay analysis
Higher Product Margins
Due to optimized batch production
$1 Million Cost Savings
Due to reduction in man-hours for assay analysis
16% Reduction
In clinical trial completion timelines
Why Us?
Domain Expertise
Domain depth powered by our strategic ecosystem – spanning LabVantage (a global leader in LIMS), BioMax (pioneers in semantic knowledge discovery), and TCG LifeSciences (a key player in clinical research)—all united under the TCG umbrella
Knowledge Graph-Powered Precision
Security, Flexibility, and Scalability
Rapid Deployment & Accelerated Outcomes
How can you engage with us?
Consultation Workshop | Request a ROI Impact Report | Request Demonstration
Insights

Scaling Industrial AI: A Strategic Approach to Moving Beyond Pilots

Unlocking Clinical Trial Potential with AI-Driven Transformation

The Critical Role of Data Management Systems in Clinical Trials


Revolutionizing Patient Recruitment in Clinical Trials with AI

AI-enabled site selection: Accelerating patient enrollments
Revolutionizing Flow Cytometry with AI and Machine Learning

Connect with our LifeSciences Experts
Soumyopriyo Saha
Senior Director – Head of Global AI Sales and Alliances